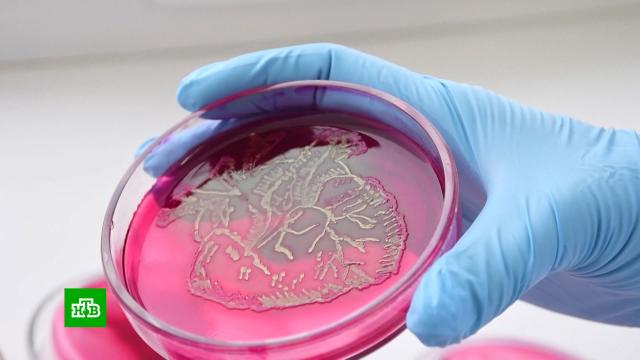

Российские микробиологи показали, как с помощью бактерий можно писать картины. Для создания изображения нужны лабораторные сосуды, микроорганизмы разных цветов и инструменты. Работа занимает всего несколько часов, рисунок проявляется через пару дней. Живет такое искусство тоже недолго.
Вместо кисти — бактериологическая петля, вместо холста — чашка Петри с питательной средой. Красок не видно, но они есть: будущие врачи в кемеровском медуниверситете рисуют кишечной палочкой. Это искусство называется
Творческая мастерская на кафедре микробиологии собирает все больше участников. На первых порах художники лишь переводят уже готовые картинки.
Сразу по окончании работы не видно, получилось красиво или нет: рисунок проявляется через сутки. Когда картинка созреет, преподаватели и студенты собираются, чтобы оценить результат.